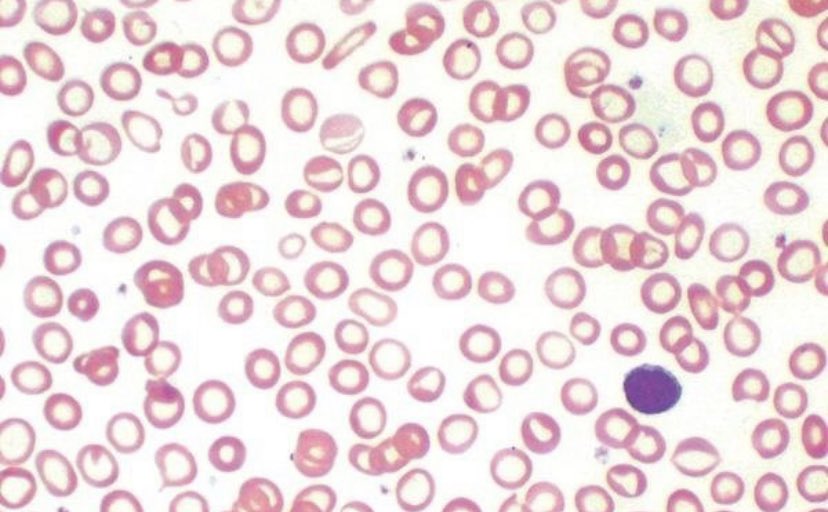

ونختم بالقول أن ليس كل من لديه أعراض في المعدة (أعلى البطن) وهو حامل للبكتيريا تكون البكتيريا هي السبب، ونذكر أن بعض الدراسات استنتجت أنه نحتاج لعلاج 14 شخصا مصابا بالبكتيريا، حتى تزول الأعراض لدى واحد فقط.
جاري تحميل الاقتراحات...